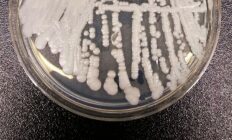

- Saltar a la navegación principal
- Saltar al contenido principal
- Saltar a la barra lateral principal
- Saltar al pie de página
Esta información está dirigida exclusivamente a los profesionales sanitarios facultados para prescribir o dispensar medicamentos, es necesaria una formación especializada para su correcta interpretación.
Footer
ADVERTENCIA
La información que figura en esta edición digital está dirigida exclusivamente al profesional destinado a prescribir o dispensar medicamentos por lo que se requiere una formación especializada para su correcta interpretación.
Consulta los últimos webinars en nuestra página, dónde podrás visualizar los contenidos anteriores
CAMPUS FARMACOSALUD
Portal de formación online. Ponte en contacto con nosotros para cualquier duda en nuestro mail cursos@campusfarmacosalud.com
Actualización más reciente: jueves, 9 de abril de 2026
https://www.farmacosalud.com está inscrita como soporte válido en el Registro de la Generalitat de Catalunya, Departamento de Salud.
Actualizado a fecha 17/07/2022 con el código farmacosalud-2VHB9XVC3.
Actualizado a fecha 17/07/2022 con el código farmacosalud-2VHB9XVC3.
FARMACOSALUD.COM es un medio de comunicación que difunde información médico-sanitaria dirigida a profesionales sanitarios, por lo que NO RESPONDEMOS a consultas concretas sobre casos médicos o asistenciales particulares. Las noticias que publicamos no sustituyen a la información, el diagnóstico y/o tratamiento o a las recomendaciones QUE DEBE FACILITAR UN PROFESIONAL SANITARIO ante una situación asistencial determinada.
FARMACOSALUD.COM no se hace responsable ni considera como propias, las opiniones vertidas por los profesionales en la citada web, desde declaraciones, podcasts, videos a publicaciones científicas que vienen firmadas por autor.
FARMACOSALUD.COM no se hace responsable ni considera como propias, las opiniones vertidas por los profesionales en la citada web, desde declaraciones, podcasts, videos a publicaciones científicas que vienen firmadas por autor.
© 2026 farmacosalud